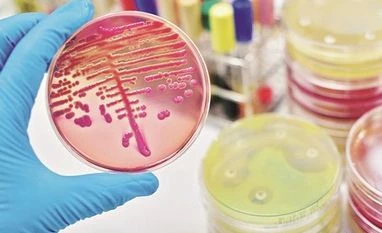
Pharma stocks rally; Nifty Pharma index surges 10%, Ipca Labs hits new high pharma
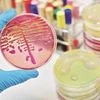
pharma

The ban on export of hydroxychloroquine (HCQ) -- claimed to be effective to treat coronavirus (COVID-19) -- may also be lifted, Business Standard said in a report.
At 11:37 am, Nifty Pharma -- the top gainer among sectoral indices -- was up 10 per cent at 8,095, as compared to 5.2 per cent rise in the Nifty 50 index. In the past two trading days, the pharma index has risen 15 per cent, against 3 per cent gain in the benchmark index.
Among individual stocks, Cadila Healthcare, Dr Reddy’s Laboratories, Aurobindo Pharma, Cipla, Glenmark Pharmaceuticals, Lupin, Alembic Pharmaceuticals, Laurus Labs, Torrent Pharmaceuticals, Ipca Laboratories and Sun Pharmaceutical Industries were up 8 per cent to 15 per cent on the NSE.
Shares of Torrent Pharmaceuticals (up 15 per cent to Rs 2,380) and Ipca Labs (up 15 per cent to Rs 1,600) hit their respective new highs, while Dr Reddy’s Laboratories too surged 15 per cent to Rs 3,461, touching a fresh 52-week high on the NSE.
Meanwhile, analysts at Nirmal Bang Securities expect the January-March quarter (Q4FY20) earnings to be monotonous for most pharma companies. The brokerage does not see a meaningful adverse impact of COVID-19 lockdown on earnings.
“With China resuming supplies of raw materials, potential disruption in manufacturing is now no longer a concern. There has been inflation in select raw material supplies but the same should only have a minor impact on gross margins during the quarter,” the brokerage's analysts said in a result preview.
The India pharma market growth continues on expected lines – high single digit. In the US, we could see marginal benefit coming from USD appreciation and potential increase in stocking at the wholesaler level which should be offset by currency depreciation in emerging markets due to declining crude prices, the report said.
Analysts at Centrum Broking remain confident on the strong demand scenario from both domestic and export markets. They also believe that these disruptions would not be meaningful from full year earnings perspective as the benefits of weaker currency could bridge the gap.
“The global turmoil has led to many striking value buying opportunities in the sector. Most of the large corporates are trading at less than 2 times market cap/sales under our coverage. The opportunities even from pure domestic piece of the business are trading cheap,” the brokerage firm said in sector update. It continues to prefer Sun Pharma, Aurobindo Pharma and Dr Reddy’s among large caps given the strength of the balance sheet and opportunity base.
One subscription. Two world-class reads.
Already subscribed? Log in
Subscribe to read the full story →
Smart Quarterly
₹900
3 Months
₹300/Month
Smart Essential
₹2,700
1 Year
₹225/Month
Super Saver
₹3,900
2 Years
₹162/Month
Renews automatically, cancel anytime
Here’s what’s included in our digital subscription plans
Exclusive premium stories online
Over 30 premium stories daily, handpicked by our editors


Complimentary Access to The New York Times
News, Games, Cooking, Audio, Wirecutter & The Athletic
Business Standard Epaper
Digital replica of our daily newspaper — with options to read, save, and share


Curated Newsletters
Insights on markets, finance, politics, tech, and more delivered to your inbox
Market Analysis & Investment Insights
In-depth market analysis & insights with access to The Smart Investor


Archives
Repository of articles and publications dating back to 1997
Ad-free Reading
Uninterrupted reading experience with no advertisements


Seamless Access Across All Devices
Access Business Standard across devices — mobile, tablet, or PC, via web or app
)